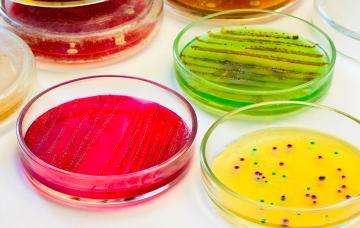
Tipos de candidiasis en muestras de laboratorio Tipos de candidiasis
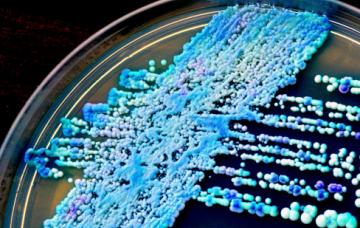
Causas de candidiasis Causas de candidiasis

Candidiasis

Por: David Saceda Corralo
Médico Interno Residente, especialista en Dermatología Medicoquirúrgica y Veneorología
Por: Dr. José Antonio Nuevo González
Especialista en Medicina Interna. Servicio de Urgencias del Hospital Gregorio Marañón de Madrid
- 1

Qué es la candidiasis
Las candidiasis son infecciones de la piel y mucosas por un hongo llamado Candida. Te explicamos qué zonas son las más afectadas y cómo evitar recidivas.
Leer más - 2

Tipos de candidiasis
Estos son los tipos de candidiasis existentes. Conoce dónde pueden localizarse (piel, boca, aparato digestivo, reproductor…) y sus características.
Leer más - 3

Causas de candidiasis
Una candidiasis invasora ocurre tras un aumento de Candida en la flora de boca, vagina y heces. Puede aparecer tras tomar antibióticos, pero hay más causas.
Leer más - 4

Diagnóstico de la candidiasis
El diagnóstico de candidiasis se basa en los síntomas y lesiones característicos, pero también se pueden tomar muestras o biopsias para identificar el hongo.
Leer más - 5

Tratamiento de la candidiasis
En el tratamiento de la candidiasis se usan antifúngicos por vía oral o tópica con el fin de eliminar la Candida. Existen más opciones según la infección.
Leer más - 6

Prevención de la candidiasis
Para prevenir un caso de candidiasis hay que recordar que una buena higiene y un buen estado de salud impiden la invasión de piel y mucosas por Candida.
Leer más